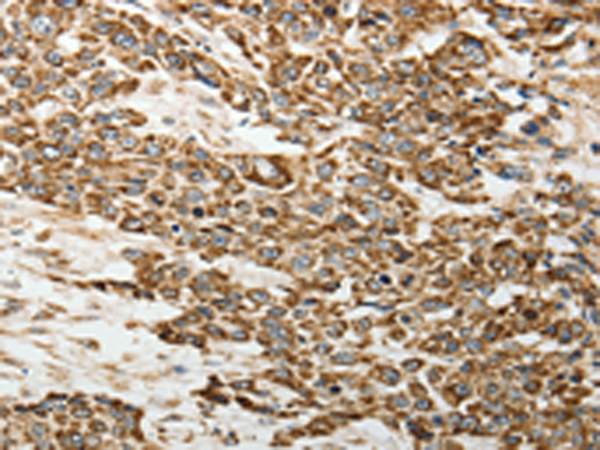
一抗

中文名稱:兔抗SELE多克隆抗體
英文名稱: Anti-SELE rabbit polyclonal antibody
別 名: ELAM; ESEL; CD62E; ELAM1; LECAM2
抗 原: SELE
儲 存: 冷凍(-20℃)
宿 主: Rabbit
相關(guān)類別: 一抗
反應(yīng)種屬: Human
標(biāo)記物: Unconjugate
克隆類型: rabbit polyclonal
技術(shù)規(guī)格
|
Background: |
The protein encoded by this gene is found in cytokine-stimulated endothelial cells and is thought to be responsible for the accumulation of blood leukocytes at sites of inflammation by mediating the adhesion of cells to the vascular lining. It exhibits structural features such as the presence of lectin- and EGF-like domains followed by short consensus repeat (SCR) domains that contain 6 conserved cysteine residues. These proteins are part of the selectin family of cell adhesion molecules. Adhesion molecules participate in the interaction between leukocytes and the endothelium and appear to be involved in the pathogenesis of atherosclerosis. |
|
Applications: |
ELISA, IHC |
|
Name of antibody: |
SELE |
|
Immunogen: |
Fusion protein of human SELE |
|
Full name: |
selectin E |
|
Synonyms: |
ELAM; ESEL; CD62E; ELAM1; LECAM2 |
|
SwissProt: |
P16581 |
|
ELISA Recommended dilution: |
2000-5000 |
|
IHC positive control: |
Human esophagus cancer and Human lung cancer |
|
IHC Recommend dilution: |
50-200 |

 購物車
購物車 幫助
幫助
 021-54845833/15800441009
021-54845833/15800441009